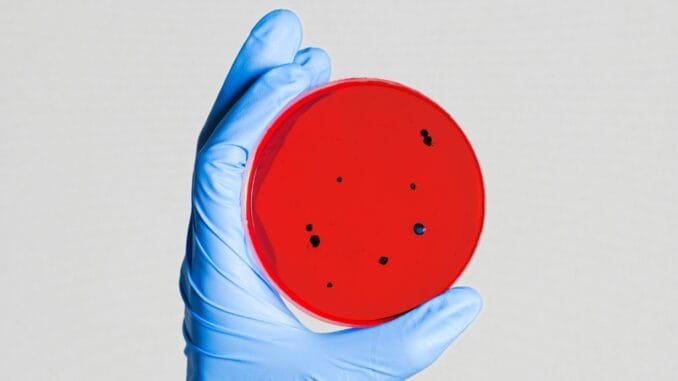

Kanserli hücrelere etki ederek bu hücreleri öldüren yeni bir tür kanser tedavisi, insanlar üzerindeki ilk denemelerde ciddi umutlar vaat eden sonuçlar verdi.
İngiltere’den bilim insanlarının yaptığı açıklamaya göre bir kanser hastasının tüm kanserli hücreleri yok olurken diğerlerinin kanserli tümörleri küçüldü.
Virüs, uçuk virüsünün zayıflatılmış bir formu; bu formun üzerinde de tümörleri öldüreceği şekilde oynandı.
Tedavinin gerçek anlamda sonuç verip vermediğini görmek için daha uzun süreli ve geniş çaplı çalışmalara ihtiyaç var. Ancak BBC’nin sağlık editörü Michelle Roberts, uzmanların, bu aşamada bile virüslerin kanser hastalarına enjekte edilmesi halinde kanseri ilerlemiş hastalara bile iyileşme umudu olabileceğini söylüyor.
Araştırma, İngiltere’nin Ulusal Sağlık Hizmetleri’ne bağlı (NHS) Kraliyet Marsden Kuruluşu’ndaki Kanser Araştırma Enstitüsü tarafından yürütülüyor.
Londra’nın batısında yaşayan 39 yaşındaki Krzysztof Wojkowski, çalışmanın şu an devam eden aşamasına katılan hastalardan biri.
2017’de ağız bölgesinde, tükürük bezlerine kanser teşhisi konulan Wojkowski, birçok ameliyat ve tedavi gördüğü halde kanseri yenemedi. Aksine hastalık daha da ilerledi.
“Bana başka bir seçeneğim olmadığı söylendi, artık yoğun bakımda tedavi altındaydım. Çok yıkıcı bir durumdu, bu sebeple bu çalışmaya katılma şansı verilmesi inanılmaz bir durum oldu.”
Virüs tedavisinin kısa bir aşamasında vücudundaki kanserli hücrelerin tümünün temizlendiği görüldü:
“İki haftada bir iğne vuruldum, toplam beş hafta sürdü. Şu an bunun üzerinden iki yıl geçti ve atık vücudumda kanserli hücre yok.”
Doğrudan tümöre yapılan iğneler, kanserli hücrelere iki şekilde saldırıyor: Kanserli hücreleri kuşatıp patlatıyor; sonra da bağışıklık sistemini harekete geçiriyor.
Yaklaşık 40 hastanın katıldığı çalışmalarda bazı hastalara doğrudan RP2 adı verilen bu modifiye edilmiş, normalde uçuk çıkmasına yol açan bir soğuk algınlığı virüsü olan herpes virüsü enjekte edildi. Diğer hastalara ise bu iğnelerle birlikte aldıkları kanser ilaçları da verilmeye devam etti.
Alınan sonuçlara göre;
-Sadece RP2 verilen dokuz hastadan üçünde – Wojkowski de bunlardan biri – tümörlerin küçüldüğü tespit edildi
-Kanser ilacı da almaya devam eden 30 hastadan yedisinde tedavi olumlu sonuç verdi
-Yorgunluk gibi yan etkiler çok hafif şekilde hissedildi
Araştırma ekibinin başındaki Prof. Kevin Harrington, BBC’ye, tedavi sonuçlarının “gerçekten çok etkileyici olduğunu” söyledi ve bazı ileri seviye kanserleri de tedavi ettiğini belirtti:
“Daha tedavinin güvenilirliğini test etmek için yaptığımız bu ilk adımda, klinik araştırmanın henüz bu kadar başındayken bu kadar olumlu sonuçlar almak çok nadir görülen bir durum. Artık tedavilerine son verilmiş hastalarda da olumlu sonuçlar aldık. Araştırmaya katılan hastaların sayısı arttıkça olumlu sonuçlar almaya devam edecek miyiz, heyecanla bekliyorum.”
Bu aslında bilim insanlarının kanserle savaşmak için ilk kez virüs kullanışı değil. NHS birkaç yıl önce de ileri seviye deri kanseri için soğuk virüs temelli T-Vec adı verilen bir tedavi yöntemini onaylamıştı.
Prof. Harrington, RP2’nin T-Vec’in geliştirilmiş bir versiyonu olduğunu söylüyor:
Birleşik Krallık Kanser Araştırmaları’ndan Dr. Marianne Baker da, mevcut sonuçların bile kanser tedavisinde büyük değişiklikler yaratabileceğini söylüyor:
“Bilim insanları virüslerin kanser tedavisinde işe yarayabileceğini yaklaşık 100 yıl önce keşfetmişti. Ancak bunu güvenli ve etkili bir şekilde uygulamak çok zor oldu. Bu yeni virüs tedavisi henüz başlangıç aşamasında umut vaat ediyor, şimdi daha fazla çalışmanın yapılmasını ve tedavinin nasıl işlediğini görmemiz gerekiyor. Araştırmalar, birden çok tedavinin bir arada uygulanmasının güçlü br strateji olduğunu gösteriyor, virüs tedavisinin de bu stratejide önemli bir rol oynayabilir.”







İlk yorum yapan olun